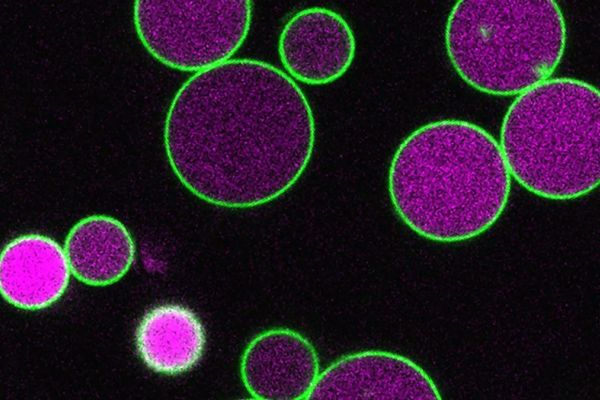

Police have arrested 41 individuals with narcotics from various locations across the country. In Kathmandu Metropolitan City–32, a teenager was taken into custody along with 130 tramadol tablets, a medication that can only be purchased on a doctor’s prescription. Confiscated items from those arrested include brown heroin, tramadol, and nitrazepam tablets. The arrests took place on April 25 in Kathmandu.
During routine patrols, police apprehended 41 suspects from different areas. In Kathmandu Metropolitan City–32, a teenager was arrested with 130 tramadol tablets and NPR 68,200 in cash. According to the Central Police News Desk, among those detained were one individual from Tikapur Municipality–1 in Kailali, two from Pahalamnpur in Ghodaghodi Municipality–10, two from Simtali Chowk in Birendranagar Municipality–8, one from Buddhbhumi Municipality–9 in Kapilvastu, two from Baschok in Inaruwa Municipality–4 in Sunsari, and two from Bhanu Chowk in Ghorahi Sub-Metropolitan City–15 in Dang, all found with brown heroin.
The suspects were arrested on Saturday. Along with cash, scales used for weighing narcotics were also seized. In Kathmandu Metropolitan City–4, Sukedhara, one person was arrested with brown heroin; two individuals at Balkhu Chok were detained along with 998 tramadol tablets and NPR 16,500 in cash. Similarly, two were arrested from Kalapani in Suryodaya Municipality–11, Ilam; nine from Bhadrapur Municipality–5 in Jhapa; two from Shivasatakshi Municipality–1; two from Bedkot Municipality–8 in Kanchanpur; two from Gaddachowki in Bhimdatta Municipality–11; two from Gobrayya in Butwal Sub-Metropolitan City–15, Rupandehi; and one from Buddhanagar in Sainamaina Municipality–5.